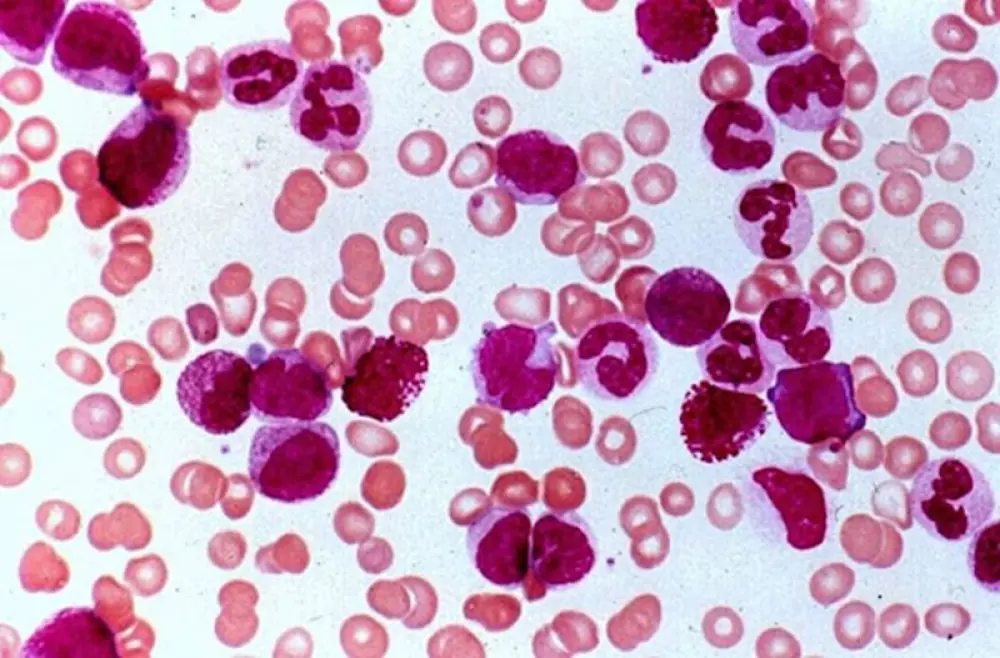

Нове дослідження, проведене під керівництвом вчених з Медичної школи Університету Індіани, виявило вразливе місце гострого мієлоїдного лейкозу, визначивши залежність цього захворювання від певного сигнального шляху, що бере участь у запальній реакції організму. Отримані в ході доклінічних досліджень дані свідчать про те, що блокування цього шляху за допомогою нового лікарського препарату може послабити гострий мієлоїдний лейкоз на критичних стадіях, відкриваючи шлях до більш ефективних і цілеспрямованих методів лікування цього захворювання.
За даними Національного інституту раку, п'ятирічна виживання при гострому мієлоїдному лейкозі (ОМЛ) становить лише 32,9%, а в 2025 році було зареєстровано близько 22 000 нових випадків. Гострий мієлоїдний лейкоз (ОМЛ) відомий своєю стійкістю до лікування та високою частотою рецидивів.
«Гострий мієлоїдний лейкоз (ОМЛ) - це складне захворювання крові, оскільки невелика популяція клітин, відомих як стовбурові клітини лейкемії, здатна виживати після хіміотерапії і згодом викликати рецидив захворювання. Метою нашого дослідження було зрозуміти критично важливі механізми, на які спираються ці стовбурові клітини лейкемії як на етапі діагностики, так і при рецидиві, а також визначити потенційні терапевтичні мішені» - Цзу-Ч'є (Кейт) Хо, доктор філософії, доцент кафедри педіатрії медичної школи Універсій.
У дослідженні, опублікованому в журналі Leukemia, вчені вивчили стовбурові клітини лейкемії пацієнтів із гострим мієлоїдним лейкозом (ОМЛ) на етапах діагностики та рецидиву. Вони виявили, що запальний сигнальний шлях, що бере участь у реакції імунної системи організму, відомий як сигнальний шлях інтерлейкіну-1 (IL-1), значно підвищений на обох етапах. Коли команда використовувала генетичні підходи зниження цього сигналу в клітинах ОМЛ людини, клітини утворювали менше колоній і демонстрували знижену здатність до повторного розвитку лейкемії.
Дослідники також розробили нову лікарську сполуку, UR241-2, призначену для блокування ключових білків, що беруть участь у сигнальному шляху IL-1. У доклінічних моделях ця сполука вражала стовбурові клітини лейкемії, значною мірою не торкаючись здорових кровотворних клітин, і суттєво знижувала рівень лейкемії у мишей. Їхні результати показують, що вплив на цей сигнальний шлях може посилити існуючі методи лікування ОМЛ, такі як хіміотерапія, та знизити ризик рецидиву.
«Наші дослідження показують, що передача сигналів IL-1 не є випадковим явищем, а є фундаментальним механізмом виживання, який зберігається на різних стадіях ОЛМ і може бути використаний як мішень», — сказав Рубен Капур, доктор філософії, директор Центру педіатричних досліджень ім. Германа Б. Уеллса при Медичній школі Університету Індіани та співавтор дослідження. «Це відкриває захоплюючі можливості для розробки більш ефективних та точних методів лікування».
Препарат UR241-2 знаходиться на ранній стадії доклінічних досліджень, але аналогічні ліки вже проходять клінічні випробування при інших видах раку та імунозалежних захворюваннях, що вказує на перспективність подальшого вивчення цієї сполуки при гострому мієлоїдному лейкозі.
"У майбутньому в лікуванні ОМЛ може бути застосована наша стратегія поряд зі стандартною хіміотерапією для зниження ризику рецидиву", - сказав Хо. «Ми сподіваємося, що ці підходи зрештою допоможуть покращити результати лікування та довгостроковий прогноз для пацієнтів із ОМЛ».
Хо і Капур також є дослідниками у програмі гематологічних злоякісних новоутворень та біології стовбурових клітин Центру Уеллса та у Комплексному онкологічному центрі ім. Мелвіна і Брен Саймон при Індіанському університеті.
Джерело: Медична школа Індіанського університету